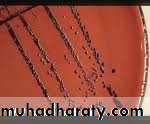

Corynebacterium diphtheriae
Dr.ghada younisCorynebacterium
ClassificationCorynebacterium diphtheriae and diphtheroids are Gram+ve , club shaped rods.
Some are saprophytic
Some produce disease in animals.
C. diphtheriae is the most important pathogen in the group.
Morphology and cultural characteristics
Small G+B; arrangement=palisade or Chinese letters
Growth on B.A – raised, translucent, gray colonies
Diphtheroids Gram stain
Arrangement of C. diphtheria
Corynebacterium
Loeffler‘s agar slant contains serum and egg that enhance the formation of metachromatic granules (polymerized polyphosphoric acid) in C. diphtheriae.Also called Babes-Ernst granules.
They are visualized by staining with methylene blue.
Methylene blue stain from Loefflers slant
A medium containing tellurite should be select for Corynebacterium and other G+ organisms ,
it inhibits G-ve organisms. Two kinds are used:
Cystine tellurite has a longer shelf life
Tinsdale helps to differentiate amongst the Corynebacterium spp.
Colonies on either media appear black or gray due to tellurite reduction.
3 morphological types of C. diphtheriae are found on tellurite containing media:
Mitis – black colonies with a gray periphery
Gravis – large, gray colonies
Intermedius – small, dull gray to black.
All produce an immunologically identical toxin.
Incubation -35-370 C for 24 hours.
They prefer a pH of 7.8-8.0 for good growth.
They require access to oxygen
Biochemistry
Catalase +
Corynebacterium
NonmotileC. ulcerans is urease +, C. diphtheriae is -,
and C. pseudotuberculosis is usually +
Virulence factors C. diphtheriae
For C. diphtherias to cause diphtheria an exotoxin must be produced.
Is a heat-labile polypeptide produced during lysogeny of a phage that carries the "tox” gene.
Alkaline pH of 7.8- 8.0, aerobic conditions, and a low environmental iron level are essential for toxin production (occurs late in the growth of the organism).
The toxin inhibits protein synthesis by ADP-ribosylating elongation factor 2.
C. ulcerans and C. pseudotuberculosis sometimes make a diphtheria-like toxin.
To prove that an isolate can cause diphtheria, one must demonstrate toxin production.
This is most often done on an Elek plate:The organism is streaked on a plate containing low iron.
A filter strip containing anti-toxin antibody is placed perpendicular to the streak of the organism.
Diffusion of the antibody into the medium and secretion of the toxin into the medium occur.
At the zone of equivalence, a precipitate will form.
Elek plate( in vitro test)
(In vivo test)
Guinea pig s are usedCorynebacterium
Clinical Significance (C. diphtheria)Is normally found in the throats of healthy carriers.
The organism infects only man and it has a limited capacity to invade.
Diphtheria - Disease usually starts as a local infection of the mucous membranes causing a membranous pharyngitis
Local toxin effects result in degeneration of epithelial cells.
Inflammation, edema, and production of a pseudomembrane composed of fibrin clots, leukocytes, and dead epithelial cells and microorganisms occurs in the throat.
Diphtheria - pseudomembrane
This may obstruct the airway and result in suffocation.Corynebacterium
The more dangerous effects occur when the toxin becomes systemic and attacks the heart(heart failure), peripheral nerves (paralysis), and the adrenal glands (hypofunction).Antibiotic susceptibility and treatment
Antiserum once the toxin has bound, however, the antiserum against it is ineffective.
Penicillin to eliminate the organism.
Corynebacterium
Prevention- Active immunization with toxoid ,
Is part of the DPT vaccine.
Shick skin test
it tests for circulating antibody to the toxin by injecting a small amount of toxin intradermally and observing for a local erythematous and necrotic reaction.
If this occurs it indicates that the person has no anti-toxin antibodies and is, therefore, susceptible to diphtheria.
Other Corynebacterium are part of the normal flora of the skin and URT.
Corynebacterium
Are called diphtheroids and may occasionally cause disease, particularly in immunocompromised individuals.C. ulcerans toxigenic strains may produce a disease similar to, but less severe than diphtheria.
J-K Group commonly cause infections in those with underlying disease.
Diseases include bacteremia, meningitis, peritonitis, wound infections, etc.
It is becoming more and more of a problem.
C. pseudotuberculosis found in those with exposure to animals.
Can cause pneumonia or lymphadenitis.
Produces a different exotoxin than C. diphtheriae.
Propionibacterium
ClassificationTwo species P. acnes and P. granulosum.
Are described as anaerobic diphtheroids, though some can grow in CO2.
Most clinical isolates are P. acnes which is part of the NF of skin.
Morphology and cultural characteristics
Pleomorphic, small G+B, may have Chinese letter configurations or may be branching.
Propionibacterium
Propionibacterium
Propionibacterium
Grow well on BA, producing tiny translucent to opaque and white to gray colonies.Growth may be slow.
Anaerobic, though occasional strains of P. granulosum grow in CO2
Biochemistry
Catalase +
Indole +/-
Ferment glucose
Produce caseinase
Propionibacterium
Virulence factorsProtease
Clinical significance –
Is part of skin NF
Has been implicated in causing acne –
During adolescence more sebum is produced, and P. acnes metabolizes it to produce fatty acids.
These may contribute to the inflammatory response seen in acne.
Has also been isolated from joint infections
Propionibacterium
Antibiotic susceptibility/
treatmentTetracycline